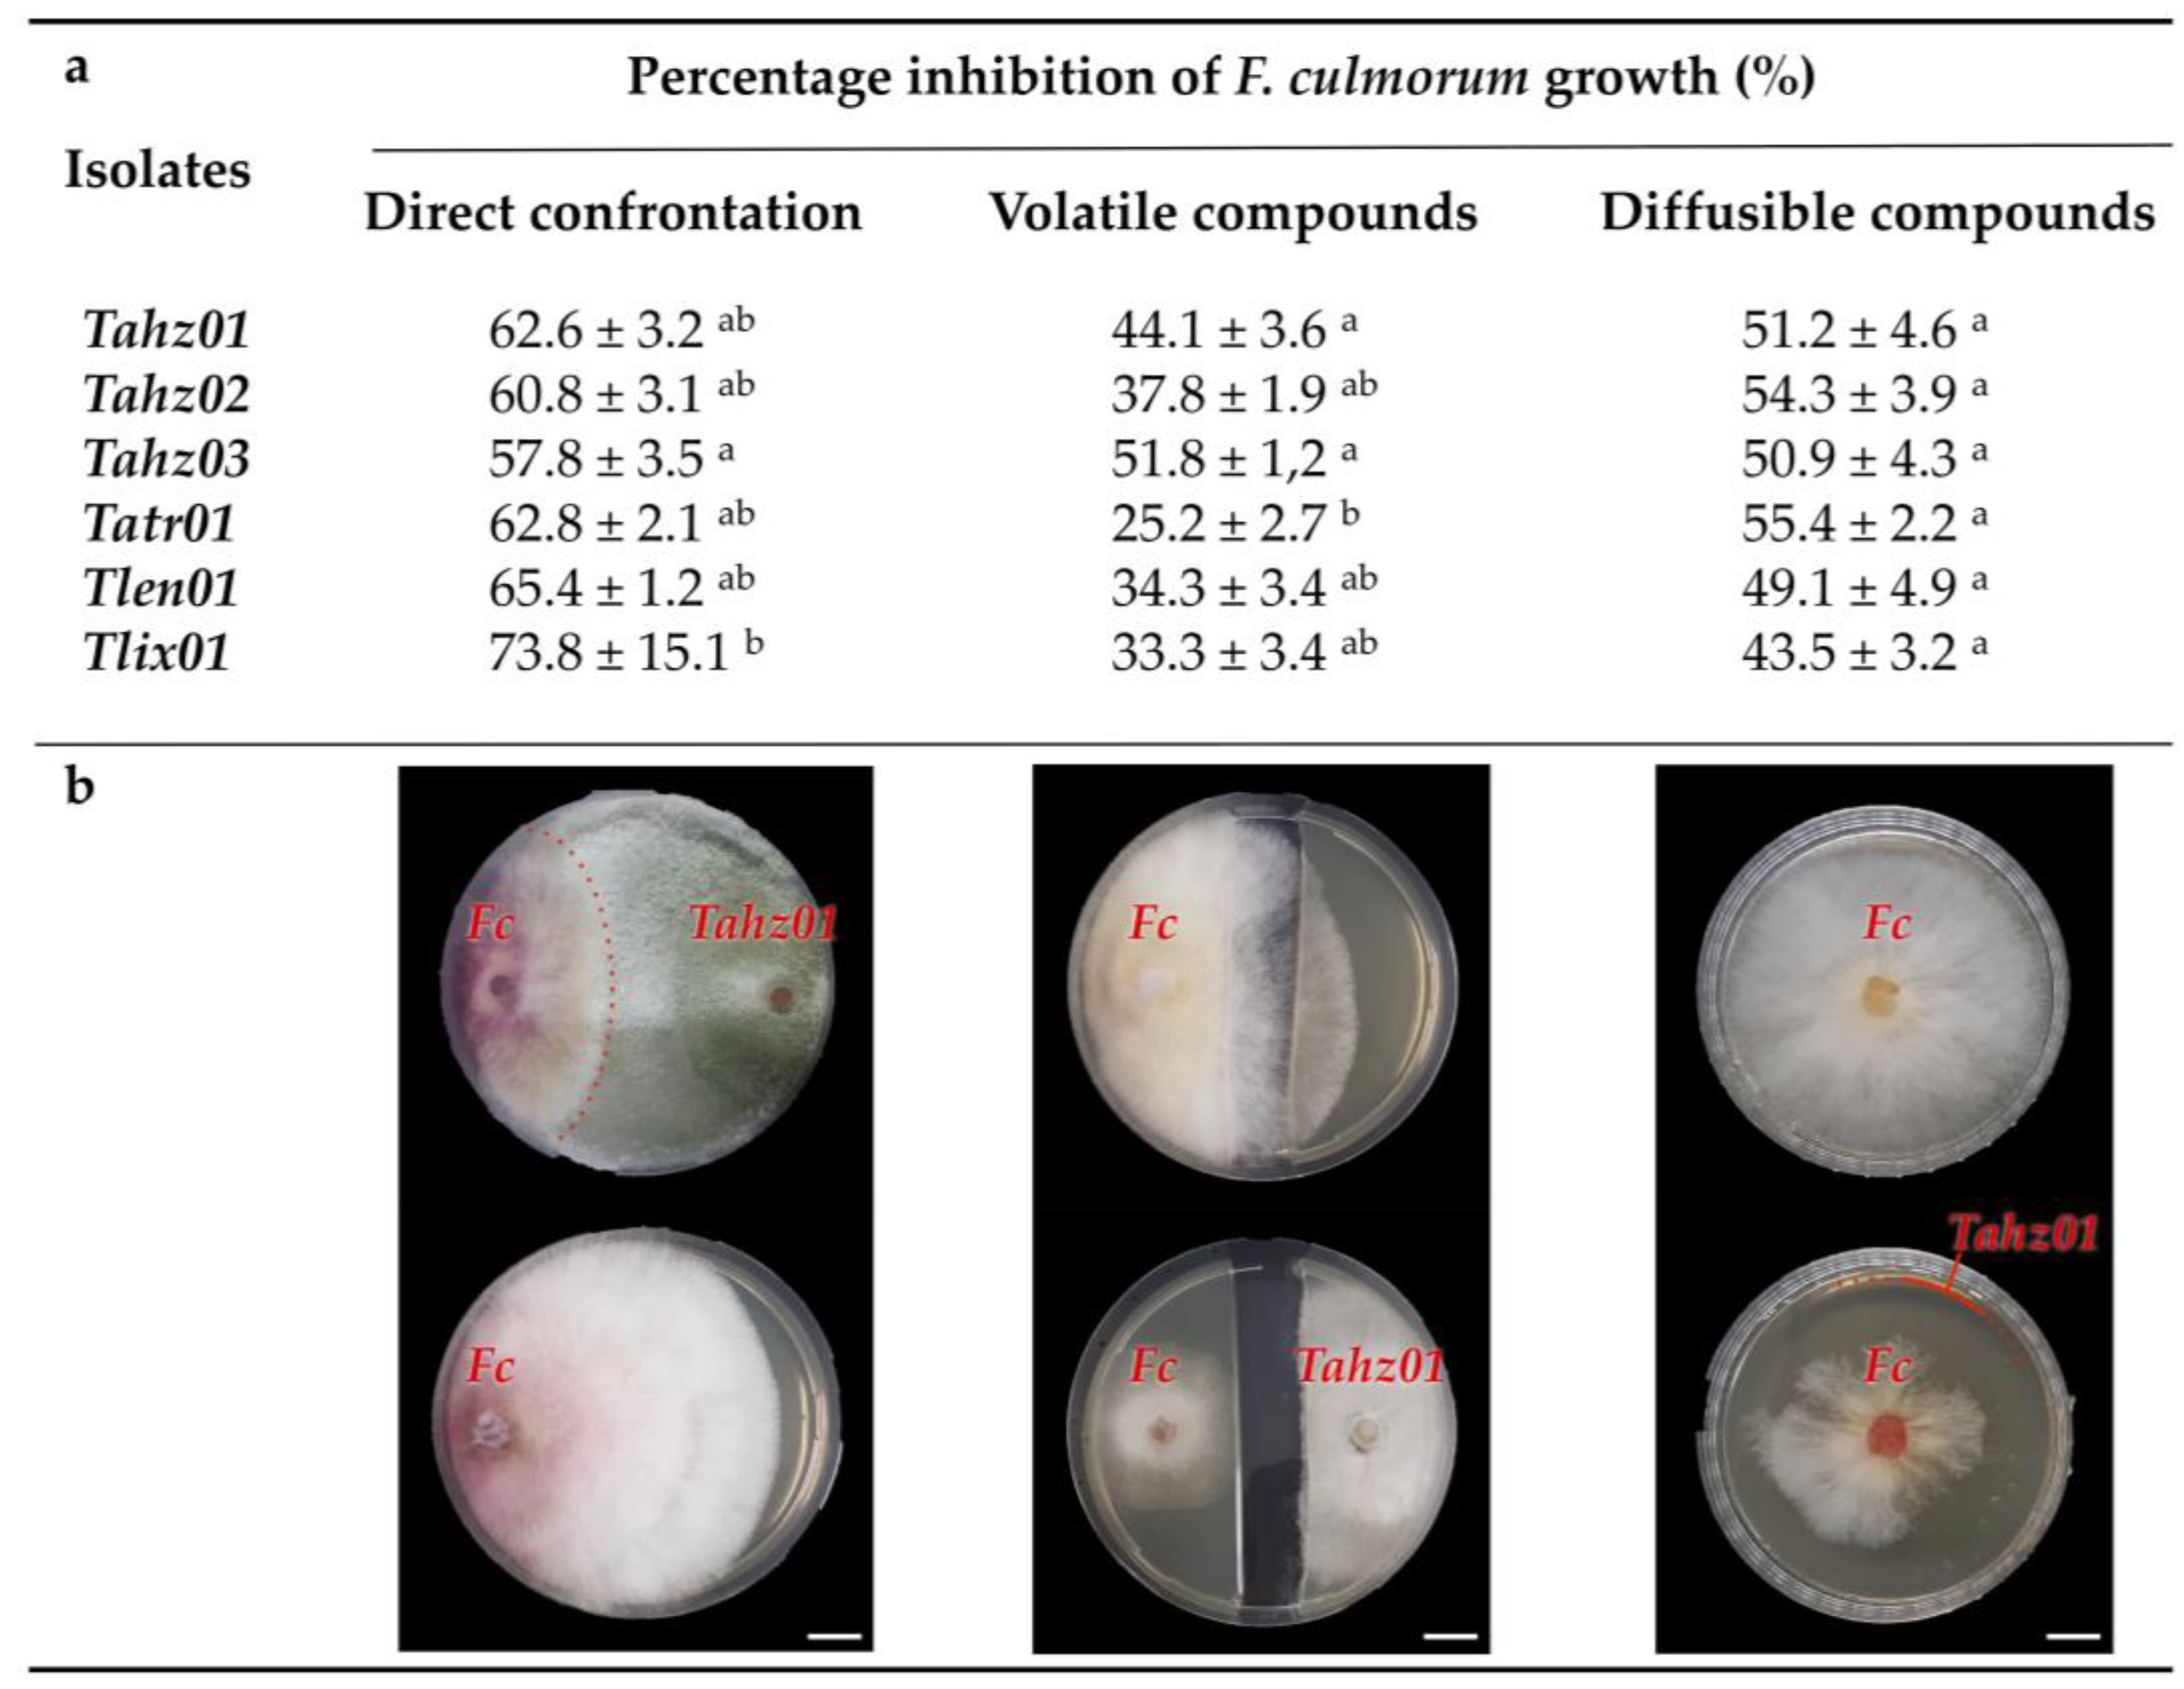
Microorganisms 11 01512 g005 Microorganisms 11 01512 g005

Assessment of Tunisian Trichoderma Isolates on Wheat Seed Germination, Seedling Growth and Fusarium Seedling Blight Suppression
Abstract
1. Introduction
2. Materials and Methods
2.1. Tunisian Sampling Location
2.2. Isolation and Culture Conditions
2.3. Molecular Identification and Bioinformatic Analyses of Trichoderma spp.
2.4. Bioassays for Antagonism Traits of Trichoderma spp. against F. culmorum
2.4.1. Plant Pathogen
2.4.2. In Vitro Confrontation Assay
2.4.3. Determination of Diffusible and Volatile Metabolite Productions
2.4.4. Qualitative Determination of Detoxifying and Lytic Enzyme Production
2.5. Bioassays for Plant Growth Promoting Traits
2.5.1. Solubilization of Inorganic Phosphate
2.5.2. Colorimetric Detection of Indole-Related Compounds
2.5.3. Hydrogen Cyanide (HCN) Production
2.5.4. Ammonia Production
2.6. Bioassay of Trichoderma Strains for Plant Growth Promoting and Fusarium Seedling Blight Disease Suppression
2.6.1. Effect on Seed Germination in Axenic Conditions
2.6.2. Effect on Seedling Growth under Greenhouse Conditions
2.6.3. Measurements of Total Chlorophyll, Epidermal Flavonols, Nitrogen Balance Index (NBI)
2.6.4. Total RNA Isolation, cDNA Synthesis, and Quantification of the Defense-Encoding Gene Accumulation
2.6.5. PCR Detection of Trichoderma and F. culmorum Strains in Wheat Roots and Leaves
2.7. PCR Statistical Analysis
3. Results and Discussion
3.1. Phylogenetic Position of the Trichoderma Isolates
3.2. Trichoderma Isolates Exhibit Differential PGP Abilities
3.3. Trichoderma Isolates Exhibit Differential Biochemical Potentials
3.4. Trichoderma Isolates Exhibit Functional BCA Abilities against F. culmorum
3.4.1. Trichoderma Isolates Annihilate the Expression of Fusarium Seedling Blight Disease (FSB) Symptoms in Wheat
3.4.2. Trichoderma Display Antagonistic Abilities In Vitro against F. culmorum Growth
3.4.3. Trichoderma Strains Stimulate the Wheat Immune Responses
General Consideration
Trichoderma Isolates Stimulate the Systemic Accumulation of Wheat Defenses
Trichoderma Isolates Influence the Wheat Phytohormone Balances
3.5. Long-Lasting Root Installation of Trichoderma Isolates for a Sustainable Plant Protection
4. Conclusions
Supplementary Materials
Author Contributions
Funding
Data Availability Statement
Acknowledgments
Conflicts of Interest
References
- Huffman, W.E.; Evenson, R.E. Structural and productivity change in US agriculture, 1950–1982. Agric. Econ. 2001, 24, 127–147. [Google Scholar] [CrossRef]
- Weese, D.J.; Heath, K.D.; Dentinger, B.T.; Lau, J.A. Long-term nitrogen addition causes the evolution of less-cooperative mutualists. Evolution 2015, 69, 631–642. [Google Scholar] [CrossRef] [PubMed]
- Vaccino, P.; Laino, P.; Limonta, M.; Gerna, D.; Vaccino, P. Morpho-physiolological and qualitative traits of a bread wheat collection spanning a century of breeding in Italy. Biodivers. Data J. 2015, 3, e4760. [Google Scholar] [CrossRef] [PubMed]
- Slama, A.; Ben Salem, M.; Ben Naceur, M.; Zid, E. Les céréales en Tunisie: Production, effet de la sécheresse et mécanismes de résistance. Sécheresse 2005, 16, 225–229. [Google Scholar]
- ONAGRI. Observatoire Nationale de l’Agriculture, Annuaire Statistique; ONAGRI: Tunis, Tunisia, 2016; 190p. [Google Scholar]
- Gargouri, S.; Hajlaoui, M.R.; Guermech, A.; Marrakchi, M. Identification des espèces fongiques associées à la pourriture du pied du blé et étude de leur répartition selon les étages bioclimatiques en Tunisie. Bull. OEPP/EPPO Bull. 2001, 31, 499–503. [Google Scholar] [CrossRef]
- Wiese, M.V. Compendium of Wheat Diseases; The American Phytopathological Society: St. Paul, MN, USA, 1987; 112p. [Google Scholar]
- Hollaway, G.J.; Evans, M.L.; Wallwork, H.; Dyson, C.B.; McKay, A.C. Yield Loss in Cereals, Caused by Fusarium culmorum and F. pseudograminearum, Is Related to Fungal DNA in Soil Prior to Planting, Rainfall, and Cereal Type. Plant Dis. 2013, 97, 977–982. [Google Scholar] [CrossRef]
- Antalová, Z.; Bleša, D.; Martinek, P.; Matušinsky, P. Transcriptional analysis of wheat seedlings inoculated with Fusarium culmorum under continual exposure to disease defense inductors. PLoS ONE 2020, 15, e0224413. [Google Scholar] [CrossRef]
- Khemir, E.; Chekali, S.; Moretti, A.; Gharbi, M.S.; Allagui, M.B.; Gargouri, S. Survival of Fusarium culmorum, causal agent of foot and root rot of cereals, on wheat, barley and oat residues in Tunisia. Ann. L’INRAT 2018, 91, 162–172. [Google Scholar]
- Simpson, D.R.; Thomsett, M.A.; Nicholson, P. Competitive interactions between Microdochium nivale var. majus, M. nivale var. nivale and Fusarium culmorum in planta and in vitro. Environ. Microbiol. 2004, 6, 79–87. [Google Scholar] [CrossRef]
- Li, X.; Zhang, J.B.; Song, B.; Li, H.P.; Xu, H.Q.; Qu, B.; Dang, F.J.; Liao, Y.C. Resistance to Fusarium head blight and seedling blight in wheat is associated with activation of a cytochrome P450 gene. Phytopathology 2010, 100, 183–191. [Google Scholar] [CrossRef]
- Pirgozliev, S.R.; Edwards, S.; Hare, M.C.; Jenkinson, P. Strategies for the control of Fusarium head blight in cereals. Eur. J. Plant Pathol. 2003, 109, 731–742. [Google Scholar] [CrossRef]
- Dal Bello, G.M.; Mónaco, C.I.; Simón, M.R. Biological control of seedling blight of wheat caused by Fusarium graminearum with beneficial rhizosphere microorganisms. World J. Microbiol. Biotechnol. 2002, 18, 627–636. [Google Scholar] [CrossRef]
- Khemir, E.; Chekali, S.; Moretti, A.; Gharbi, M.S.; Allagui, M.B.; Gargouri, S. Impacts of previous crops on inoculum of Fusarium culmorum in soil, and development of foot and root rot of durum wheat in Tunisia. Phytopathol. Mediterr. 2020, 59, 187–201. [Google Scholar] [CrossRef]
- Bhaskara Reddy, M.V.; Arul, J.; Angers, P.; Couture, L. Chitosan treatment of wheat seeds induces resistance to Fusarium graminearum and improves seed quality. J. Agric. Food Chem. 1999, 47, 1208–1216. [Google Scholar] [CrossRef] [PubMed]
- Khan, M.R.; Fischer, S.; Egan, D.; Doohan, F.M. Biological control of Fusarium seedling blight disease of wheat and barley. Phytopathology 2006, 96, 386–394. [Google Scholar] [CrossRef] [PubMed]
- Wisniewska, H.; Kowalczyk, K. Resistance of cultivars and breeding lines of spring wheat to Fusarium culmorum and powdery mildew. J. Appl. Genet. 2005, 46, 35–40. [Google Scholar] [PubMed]
- Gharbi, M.S.; El Felah, M. Les céréales en Tunisie: Plus d’un siècle de recherche variétale. Ann. L’INRAT 2013, 86, 45–68. [Google Scholar]
- Giorgi, F. Climate change hot-spots’. Adaptation to climate change: Development of a national strategy for agriculture, ecosystems and water resources in Tunisia 2005 to December. Geophys. Resour. Lett. 2007, 33, 707–715. [Google Scholar]
- Woo, S.L.; Ruocco, M.; Vinale, F.; Nigro, M.; Marra, R.; Lombardi, N.; Pascale, A.; Lanzuise, S.; Manganiello, G.; Lorito, M. Trichoderma-based products and their widespread use in agriculture. Open Mycol. J. 2014, 8, 71–126. [Google Scholar] [CrossRef]
- Awad-Allah, E.F.A.; Mohamed, I.A.A.; Allah, S.F.A.A.; Shams, A.H.; Elsokkary, I.H. Trichoderma Species: An Overview of Current Status and Potential Applications for Sustainable Agriculture. Indian J. Agric. Res. 2022, 1, 1–10. [Google Scholar] [CrossRef]
- Benítez, T.; Rincón, A.M.; Limón, M.C.; Codón, A.C. Biocontrol mechanisms of Trichoderma strains. Int. Microbiol. 2004, 7, 249–260. [Google Scholar] [PubMed]
- Li, N.; Alfiky, A.; Wang, W.; Islam; Nourollahi, K.; Liu, X.; Kang, S. Volatile Compound-Mediated Recognition and Inhibition between Trichoderma Biocontrol Agents and Fusarium oxysporum. Front. Microbiol. 2018, 9, 2614. [Google Scholar] [CrossRef] [PubMed]
- Mendoza-Mendoza, A.; Zaid, R.; Lawry, R.; Hermosa, R.; Monte, E.; Horwitz, B.A.; Mukherjee, P.K. Molecular dialogues between Trichoderma and roots: Role of the fungal secretome. Fungal Biol. Rev. 2018, 32, 62–85. [Google Scholar] [CrossRef]
- Halifu, S.; Deng, X.; Song, X.; Song, R.; Liang, X. Inhibitory Mechanism of Trichoderma virens ZT05 on Rhizoctonia Solani. Plants 2020, 9, 912. [Google Scholar] [CrossRef] [PubMed]
- Rao, Y.; Zeng, L.; Jiang, H.; Mei, L.; Wang, Y. Trichoderma atroviride LZ42 releases volatile organic compounds promoting plant growth and suppressing Fusarium wilt disease in tomato seedlings. BMC Microbiol. 2022, 22, 88. [Google Scholar] [CrossRef] [PubMed]
- Kaur, S.; Samota, M.K.; Choudhary, M.; Pandey, A.K.; Sharma, A.; Thakur, J. How do plants defend themselves against pathogens-Biochemical mechanisms and genetic interventions. Physiol. Mol. Biol. Plants 2022, 28, 485–504. [Google Scholar] [CrossRef]
- Sallam, N.M.A.; Eraky, A.M.I.; Sallam, A. Effect of Trichoderma spp. on Fusarium wilt disease of tomato. Mol. Biol. Rep. 2019, 46, 4463–4470. [Google Scholar] [CrossRef]
- Yuan, M.; Huang, Y.; Ge, W.; Jia, Z.; Song, S.; Zhang, L.; Huang, Y. Involvement of jasmonic acid, ethylene and salicylic acid signaling pathways behind the systemic resistance induced by Trichoderma longibrachiatum H9 in cucumber. BMC Genom. 2019, 20, 144. [Google Scholar] [CrossRef]
- Zhou, C.; Guo, R.; Ji, S.; Fan, H.; Wang, J.; Wang, Y.; Liu, Z. Isolation of Trichoderma from forestry model base and the antifungal properties of isolate TpsT17 toward Fusarium oxysporum. Microbiol. Res. 2020, 231, 126371. [Google Scholar] [CrossRef]
- Ben Amira, M.; Lopez, D.; Mohamed, A.T.; Khouaja, A.; Chaar, H.; Fumanal, B.; Gousset-Dupont, A.; Bonhomme, L.; Label, P.; Goupil, P.; et al. Beneficial effect of Trichoderma harzianum strain Ths97 in biocontrolling Fusarium solani causal agent of root rot disease in olive trees. Biol. Control. 2017, 110, 70–78. [Google Scholar] [CrossRef]
- Kthiri, Z.; Ben Jabeur, M.; Machraoui, M.; Gargouri, S.; Hiba, K.; Hamada, W. Coating seeds with Trichoderma strains promotes plant growth and enhance the systemic resistance against Fusarium crown rot in durum wheat. Egypt. J. Biol. Pest Control 2020, 30, 139. [Google Scholar] [CrossRef]
- Boamah, S.; Zhang, S.; Xu, B.; Li, T.; Calderón-Urrea, A. Trichoderma longibrachiatum (TG1) Enhances Wheat Seedlings Tolerance to Salt Stress and Resistance to Fusarium pseudograminearum. Front. Plant Sci. 2021, 12, 1–17. [Google Scholar] [CrossRef] [PubMed]
- Kthiri, Z.; Ben Jabeur, M.; Harbaoui, K.; Karmous, C.; Chamekh, Z.; Chairi, F.; Serret, M.D.; Araus, J.L.; Hamada, W. Comparative Performances of Beneficial Microorganisms on the Induction of Durum Wheat Tolerance to Fusarium Head Blight. Microorganisms 2021, 9, 2410. [Google Scholar] [CrossRef] [PubMed]
- Bissett, J. A revision of the genus Trichoderma. II. Infrageneric classification. J. Bot. 1991, 69, 2357–2373. [Google Scholar] [CrossRef]
- Chaverri, P.; Castlebury, L.A.; Samuels, G.J.; Geiser, D.M. Multilocus Phylogenetic Structure within the Trichoderma harzianum/Hypocrea lixii Complex. Mol. Phylogenetics Evol. 2002, 27, 302–313. [Google Scholar] [CrossRef]
- Chaverri, P.; Branco-Rocha, F.; Jaklitsch, W.; Gazis, R.; Degenkolb, T.; Samuels, G.J. Systematics of the Trichoderma harzianum species complex and the re-identification of commercial biocontrol strains. Mycologia 2015, 107, 558–590. [Google Scholar] [CrossRef]
- Zadoks, J.C.; Chang, T.T.; Konzak, C.F. A decimal code for the growth stages of cereals. Weed Res. 1974, 14, 415–421. [Google Scholar] [CrossRef]
- Elad, Y.; Chet, I.; Henis, Y.A. A selective medium for improving quantitative isolation of Trichoderma spp. from soil. Phytoparasitica 1981, 9, 59–67. [Google Scholar] [CrossRef]
- Doyle, J.J.; Doyle, J.L. A rapid DNA isolation procedure for small quantities of fresh leaf tissue. Phytochem. Bull. 1987, 19, 11–15. [Google Scholar]
- White, T.J.; Bruns, T.; Lee, S.J.; Taylor, J. Amplification and Direct Sequencing of Fungal Ribosomal RNA Genes for Phylogenetics. In PCR Protocols: A Guide to Methods and Applications; Innis, M.A., Gelfand, D.H., Sninsky, J., White, T.J., Eds.; Academic Press: New York, NY, USA, 1990; pp. 315–322. [Google Scholar]
- Carbone, I.; Kohn, L.M. A method for designing primer sets for speciation studies in filamentous ascomycetes. Mycologia 1999, 91, 553–556. [Google Scholar] [CrossRef]
- Jaklitsch, W.M.; Komon, M.; Kubicek, C.P.; Druzhinina, I.S. Hypocrea voglmayrii sp. nov. from the Austrian Alps represents a new phylogenetic clade in Hypocrea/Trichoderma. Mycologia 2005, 97, 1365–1378. [Google Scholar] [CrossRef] [PubMed]
- Liu, Y.J.; Whelen, S.; Hall, B.D. Phylogenetic relationships among ascomycetes: Evidence from an RNA polymerse II subunit. Mol. Biol. Evol. 1999, 16, 1799–1808. [Google Scholar] [CrossRef] [PubMed]
- Skidmore, A.M.; Dickinson, C.H. Colony interactions and hyphal interference between Septoria Nodorum and phylloplane fungi. Trans. Br. Mycol. Soc. 1976, 66, 57–64. [Google Scholar] [CrossRef]
- Dennis, C.; Webster, J. Antagonistic properties of species-Groups of Trichoderma: II. Production of volatile antibiotics. Trans. Br. Mycol. Soc. 1971, 57, 363–369. [Google Scholar] [CrossRef]
- Mahfooz, M.; Dwedi, S.; Bhatt, A.; Raghuvanshi, S.; Bhatt, M.; Agrawal, P.K. Evaluation of Antifungal and Enzymatic Potential of Endophytic Fungi Isolated from Cupressus torulosa D. Don. Int. J. Curr. Microbiol. Appl. Sci. 2017, 6, 4084–4100. [Google Scholar] [CrossRef]
- Bhardwaj, A.; Sharma, D.; Jadon, N.; Agrawal, P.K. Antimicrobial and phytochemical screening of endophytic fungi isolated from spikes of Pinus rouxburghii. Arch. Clin. Microbiol. 2015, 6, 1. [Google Scholar]
- López, A.C.; Alvarenga, A.E.; Zapata, P.D.; Luna, M.F.; Villalba, L.L. Trichoderma spp. from Misiones, Argentina: Effective fungi to promote plant growth of the regional crop Ilex paraguariensis St. Hil. Mycology 2019, 10, 210–221. [Google Scholar] [CrossRef]
- Roberts, W.K.; Selitrennikoff, C.P. Plant and Bacterial Chitinases Differ in Antifungal Activity. J. Fish Biol. 1988, 24, 125–134. [Google Scholar] [CrossRef]
- Coniglio, R.O.; Fonseca, M.I.; Villalba, L.L.; Zapata, P.D. Screening of new secretory cellulases from different supernatants of white rot fungi from Misiones, Argentina. Mycology 2017, 8, 1–10. [Google Scholar] [CrossRef]
- Pikovskaya, R.I. Mobilization of phosphorus in soil in connection with the vital activity of some microbial species. Mikrobiologya 1948, 17, 362–370. [Google Scholar]
- Gordon, S.A.; Weber, R.P. Colorimetric estimation of indole acetic acid. Plant Physiol. 1951, 26, 192–195. [Google Scholar] [CrossRef]
- Noori, M.S.S.; Saud, H.M. Potential plant growth-promoting activity of Pseudomonas sp. isolated from paddy soil in Malaysia as biocontrol agent. J. Plant Pathol. Microbiol. 2012, 3, 121. [Google Scholar]
- Castric, K.F.; Castric, P.A. Method for rapid detection of cyanogenic bacteria. Appl. Environ. Microbiol. 1983, 45, 700–702. [Google Scholar] [CrossRef] [PubMed]
- Rakh, R.R.; Raut, L.S.; Dalvi, S.M.; Manwar, A.V. Biological control of Sclerotium rolfsii, causing stem rot of groundnut by Pseudomonas cf. monteilii 9. Recent Res. Sci. Technol. 2011, 3, 26–34. [Google Scholar]
- Cappucino, J.C.; Sherman, N. Microbiology: A Laboratory Manual, 4th ed.; Nitrogen Cycle; Benjamin/Cumming Pub. Co.: New York, NY, USA, 1992; pp. 311–312. [Google Scholar]
- Rezgui, M.; Ben Mechlia, N.; Bizid, E.; Kalboussi, R.; Hayouni, R. Etude de La Stabilité du Rendement de Blé dur dans Différentes Régions de la Tunisie. In L’Amélioration du Blé dur dans La Région Méditerranéenne: Nouveaux Défis. Options Méditerranéennes, Série A: Séminaires Méditerranéennes; CIHEAM: Paris, France, 2000; Volume 40, pp. 167–172. [Google Scholar]
- Fernandez, M.R.; Chen, Y. Pathogenicity of Fusarium species on diferent plant parts of spring wheat under controlled conditions. Plant Dis. 2005, 89, 164–169. [Google Scholar] [CrossRef] [PubMed]
- Triveni, S.; Prasanna, R.; Shukla, L.; Saxena, A.K. Evaluating the biochemical traits of novel Trichoderma-based biofilms for use as plant growth-promoting inoculants. Ann. Microbiol. 2012, 63, 1147–1156. [Google Scholar] [CrossRef]
- Goulas, Y.; Cerovic, Z.G.; Cartelat, A.; Moya, I. Dualex: A new instrument for field measurements of epidermal ultraviolet absorbance by chlorophyll fluorescence. Appl. Opt. 2004, 43, 4488–4496. [Google Scholar] [CrossRef]
- Amira, M.B.; Mom, R.; Lopez, D.; Chaar, H.; Khouaja, A.; Pujade-Renaud, V.; Fumanal, B.; Gousset-Dupont, A.; Bronner, G.; Label, P.; et al. MIP diversity from Trichoderma: Structural considerations and transcriptional modulation during mycoparasitic association with Fusarium solani olive trees. PLoS ONE 2018, 13, e0193760. [Google Scholar]
- Livak, K.J.; Schmittgen, T.D. Analysis of relative gene expression data using real-time quantitative PCR and the 2(-Delta Delta C(T)) Method. Methods 2001, 25, 402–408. [Google Scholar] [CrossRef]
- Levene, H. Robust Tests for Equality of Variances. In Contributions to Probability and Statistics; Olkin, I., Ed.; Stanford University Press: Redwood, CA, USA; Palo Alto: Santa Clara, CA, USA, 1960; pp. 278–292. [Google Scholar]
- Fox, J.; Weisberg, S. An R Companion to Applied Regression, 3rd ed.; Sage: Thousand Oaks, CA, USA, 2019; Available online: https://socialsciences.mcmaster.ca/jfox/Books/Companion/ (accessed on 31 May 2023).
- Shapiro, S.S.; Wilk, M.B. An Analysis of Variance Test for Normality (Complete Samples). Biometrika 1965, 52, 591–611. [Google Scholar] [CrossRef]
- R Core Team. R: A Language and Environment for Statistical Computing; R Foundation for Statistical Computing: Vienna, Austria, 2022; Available online: https://www.R-project.org/ (accessed on 31 May 2023).
- Welch, B. On the Comparison of Several Mean Values: An Alternative Approach. Biometrika 1951, 38, 330–336. [Google Scholar] [CrossRef]
- Games, P.A.; Keselman, H.J.; Clinch, J.J. Tests for Homogeneity of variance in factorial designs. Psychol. Bull. 1979, 86, 978–984. [Google Scholar] [CrossRef]
- Kassambara, A. rstatix: Pipe-Friendly Framework for Basic Statistical Tests; R Package Version 0.7.1; R Project for Statistical Computing location: Vienna, Austria, 2022; Available online: https://CRAN.R-project.org/package=rstatix (accessed on 31 May 2023).
- Carroll, R.M.; Nordholm, L.A. Sampling Characteristics of Kelley’s epsilon and Hays’ omega. Educ. Psychol. Meas. 1975, 35, 541–554. [Google Scholar] [CrossRef]
- Field, F. Discovering Statistics Using IBM SPSS Statistics; Sage Publications: New York, NY, USA, 2013. [Google Scholar]
- Buchanan, E.M.; Gillenwaters, A.; Scofield, J.E.; Valentine, K. MOTE (Measure of the Effect): Package to assist in effect size calculations and their confidence intervals. 2019. Available online: http://github.com/doomlab/MOTE (accessed on 31 May 2023).
- Kruskal, W.H.; Wallis, W.A. Use of Ranks in One-Criterion Variance Analysis. J. Am. Stat. Assoc. 1952, 47, 583–621. [Google Scholar] [CrossRef]
- Tomczak, M.; Tomczak, E. The need to report effect size estimates revisited. An overview of some recommended measures of effect size. Trends Sport Sci. 2014, 1, 19–25. [Google Scholar]
- Mangiafico, S. Rcompanion: Functions to Support Extension Education Program Evaluation; R Package Version 2.4.18; R Project for Statistical Computing Location: Vienna, Austria, 2022; Available online: https://CRAN.R-project.org/package=rcompanion (accessed on 31 May 2023).
- Dunn, O.J. Multiple comparisons using rank sums. Technometrics 1964, 6, 241–252. [Google Scholar] [CrossRef]
- de Mendiburu, F. Agricolae: Statistical Procedures for Agricultural Research; R Package Version 1.3-5; R Project for Statistical Computing Location: Vienna, Austria, 2021; Available online: https://CRAN.R-project.org/package=agricolae (accessed on 31 May 2023).
- Royston, P. An extension of Shapiro and Wilk’s W test for normality to large samples. Appl. Stat. 1982, 31, 115–124. [Google Scholar] [CrossRef]
- Bartlett, M.S. Properties of sufficiency and statistical tests. Proc. R. Soc. Lond. Ser. A 1937, 160, 268–282. [Google Scholar]
- Kassambara, A. ggpubr: ‘ggplot2′ Based Publication Ready Plots_; R Package Version 0.6.0; R Project for Statistical Computing Location: Vienna, Austria, 2023; Available online: https://CRAN.R-project.org/package=ggpubr (accessed on 31 May 2023).
- Wickham, H.; Averick, M.; Bryan, J.; Chang, W.; McGowan, L.D.A.; François, R.; Grolemund, G.; Hayes, A.; Henry, L.; Hester, J.; et al. Welcome to the Tidyverse. J. Open Source Softw. 2019, 4, 1686. [Google Scholar] [CrossRef]
- Benjamini, Y.; Hochberg, Y. Controlling the False Discovery Rate: A Practical and Powerful Approach to Multiple Testing. J. Royal Statistical Soc. Ser. B Methodol. 1995, 57, 289–300. [Google Scholar] [CrossRef]
- Samuels, G.J. Trichoderma: Systematics, the sexual state, and ecology. Phytopathology 2006, 96, 195–206. [Google Scholar] [CrossRef] [PubMed]
- Feitosa, Y.B.; Cruz-Magalhães, V.; Argolo-Filho, R.C.; De Souza, J.T.; Loguercio, L.L. Characterization of genetic diversity on tropical Trichoderma germplasm by sequencing of rRNA internal transcribed spacers. BMC Res. Notes 2019, 12, 663. [Google Scholar] [CrossRef] [PubMed]
- Raja, H.A.; Miller, A.N.; Pearce, C.J.; Oberlies, N.H. Fungal Identification Using Molecular Tools: A Primer for the Natural Products Research Community. J. Nat. Prod. 2017, 80, 756–770. [Google Scholar] [CrossRef] [PubMed]
- Jaklitsch, W.M.; Voglmayr, H. Biodiversity of Trichoderma (Hypocreaceae) in Southern Europe and Macaronesia. Stud. Mycol. 2015, 80, 1–87. [Google Scholar] [CrossRef]
- Tekpinar, A.D.; Kalmer, A. Utility of various molecular markers in fungal identification and phylogeny. Nova Hedwig. 2019, 109, 187–224. [Google Scholar] [CrossRef]
- Fanelli, F.; Liuzzi, V.C.; Logrieco, A.F.; Altomare, C. Genomic characterization of Trichoderma atrobrunneum (T. harzianum species complex) ITEM 908: Insight into the genetic endowment of a multi target biocontrol strain. BMC Genom. 2018, 19, 662. [Google Scholar] [CrossRef]
- Gu, X.; Wang, R.; Sun, Q.; Wu, B.; Sun, J.-Z. Four new species of Trichoderma in the Harzianum clade from northern China. Mycokeys 2020, 73, 109–132. [Google Scholar] [CrossRef]
- Gams, W.; Bisset, J. Morphology and Identification of Trichoderma. In Trichoderma and Gliocladium: Basic Biology, Taxonomy, and Genetics; Kubicek, C.P., Harman, G.E., Ondik, K.L., Eds.; Taylor & Francis: London, UK, 2007; pp. 3–74. [Google Scholar]
- Sadfi-Zouaoui, N.; Hannachi, I.; Rouaissi, M.; Hajlaoui, M.R.; Rubio, M.B.; Monte, E.; Boudabous, A.; Hermosa, M.R. Biodiversity of Trichoderma strains in Tunisia. Can. J. Microbiol. 2009, 55, 154–162. [Google Scholar] [CrossRef]
- Yangui, I.; Boutiti, Z.; Hlaiem, S.; Vettraino, A.M.; Vannini, A.; Ben Jamaâ, M.L.; Messaoud, C. Identification and occurrence of Trichoderma harzianum associated with cork oak in Tunisia. Tunis. J. Plant Prot. 2018, 13, 39–48. [Google Scholar]
- Daami-Rreamdi, M.; Hibar, K.; Jabnoun-Khiareddine, H.; Ayed, F.; El-Mahjoub, M. Effect of Two Trichoderma species on severity of potato tuber dry rot caused by Tunisian Fusarium complex. Int. J. Agric. Res. 2006, 1, 432–441. [Google Scholar]
- Mbazia, A.; Omri Ben Youssef, N.; Kharrat, M. Tunisian isolates of Trichoderma spp. and Bacillus subtilis can control Botrytis fabae on faba bean. Biocontrol. Sci. Technol. 2016, 7, 915–927. [Google Scholar] [CrossRef]
- El-Sharkawy, H.H.; Rashad, Y.M.; Ibrahim, S.A. Biocontrol of stem rust disease of wheat using arbuscular mycorrhizal fungi and Trichoderma spp. Physiol. Mol. Plant Pathol. 2018, 103, 84–91. [Google Scholar] [CrossRef]
- Stummer, B.E.; Zhang, Q.; Zhang, X.; Warren, R.A.; Harvey, P.R. Quantification of Trichoderma afroharzianum, Trichoderma harzianum and Trichoderma gamsii inoculants in soil, the wheat rhizosphere and in planta suppression of the crown rot pathogen Fusarium pseudograminearum. J. Appl. Microbiol. 2020, 129, 971–990. [Google Scholar] [CrossRef] [PubMed]
- Junaid, J.M.; Dar, N.A.; Bhat, T.A.; Bhat, A.H.; Bhat, M.A. Commercial biocontrol agents and their mechanism of action in the management of plant pathogens. Int. J. Mod. Plant Anim. Sci. 2013, 1, 39–57. [Google Scholar]
- Harman, G.E.; Obregón, M.A.; Samuels, G.J.; Lorito, M. Changing models of biocontrol in the developing and developed world. Plant Dis. 2010, 94, 928–939. [Google Scholar] [CrossRef]
- Stummer, B.E.; Zhang, X.; Yang, H.; Harvey, P.R. Co-inoculation of Trichoderma gamsii A5MH and Trichoderma harzianum Tr906 in wheat suppresses in planta abundance of the crown rot pathogen Fusarium pseudograminearum and impacts the rhizosphere soil fungal microbiome. Biol. Control. 2022, 165, 104809. [Google Scholar] [CrossRef]
- Qiao, M.; Du, X.; Zhang, Z.; Xu, J.; Yu, Z. Three new species of soil-inhabiting Trichoderma from southwest China. Mycokeys 2018, 44, 63–80. [Google Scholar] [CrossRef]
- Pfordt, A.; Schiwek, S.; Karlovsky, P.; Von Tiedemann, A. Trichoderma Afroharzianum Ear Rot—A New Disease on Maize in Europe. Front. Agron. 2020, 2, 547758. [Google Scholar] [CrossRef]
- Cartelat, A.; Cerovic, Z.; Goulas, Y.; Meyer, S.; Lelarge, C.; Prioul, J.-L.; Barbottin, A.; Jeuffroy, M.-H.; Gate, P.; Agati, G.; et al. Optically assessed contents of leaf polyphenolics and chlorophyll as indicators of nitrogen deficiency in wheat (Triticum aestivum L.). Field Crop. Res. 2005, 91, 35–49. [Google Scholar] [CrossRef]
- Liu, Y.; Wang, J.; Xiao, Y.; Shi, X.; Zeng, Y. Diversity Analysis of Chlorophyll, Flavonoid, Anthocyanin, and Nitrogen Balance Index of Tea Based on Dualex. Phyton 2021, 90, 1549–1558. [Google Scholar] [CrossRef]
- Guler, N.S.; Pehlivan, N.; Karaoglu, S.A.; Guzel, S.; Bozdeveci, A. Trichoderma atroviride ID20G inoculation ameliorates drought stress-induced damages by improving antioxidant defense in maize seedlings. Acta Physiol. Plant. 2016, 38, 19. [Google Scholar] [CrossRef]
- Harman, G.E.; Doni, F.; Khadka, R.B.; Uphoff, N. Endophytic strains of Trichoderma increase plants’ photosynthetic capability. J. Appl. Microbiol. Biotechnol. 2021, 130, 529–546. [Google Scholar] [CrossRef] [PubMed]
- Lee, S.; Yap, M.; Behringer, G. Volatile organic compounds emitted by Trichoderma species mediate plant growth. Fungal Biol. Biotechnol. 2016, 3, 7. [Google Scholar] [CrossRef] [PubMed]
- Nieto-Jacobo, M.F.; Steyaert, J.M.; Salazar-Badillo, F.B.; Nguyen, D.V.; Rostás, M.; Braithwaite, M.; De Souza, J.T.; Jimenez-Bremont, J.F.; Ohkura, M.; Stewart, A.; et al. Environmental Growth Conditions of Trichoderma spp. Affects Indole Acetic Acid Derivatives, Volatile Organic Compounds, and Plant Growth Promotion. Front. Plant Sci. 2017, 8, 102. [Google Scholar] [CrossRef] [PubMed]
- Yedidia, I.; Shoresh, M. Concomitant induction of systemic resistance to Pseudomonas syringae pv. lachrymans in cucumber by Trichoderma asperellum (T-203) and accumulation of Phytoalexins. Appl. Environ. Microbiol. 2003, 69, 7343–7353. [Google Scholar] [CrossRef] [PubMed]
- Jayapala, N.; Mallikarjunaiah, N.; Puttaswamy, H. Rhizobacteria Bacillus spp. induce resistance against anthracnose disease in chili (Capsicum annuum L.) through activating host defense response. Egypt. J. Biol. Pest Control 2019, 29, 45. [Google Scholar] [CrossRef]
- Singh, S.P.; Keswani, C.; Singh, S.P.; Sansinenea, E.; Hoat, T.X. Trichoderma spp. mediated induction of systemic defense response in brinjal against Sclerotinia sclerotiorum. Curr. Res. Microb. Sci. 2021, 24, 100051. [Google Scholar]
- Rawat, R.; Tewari, L. Effect of abiotic stress on phosphate solubilization by biocontrol fungus Trichoderma sp. Curr. Microbiol. 2011, 62, 1521–1526. [Google Scholar] [CrossRef]
- Sawant, I.S.; Wadkar, P.N.; Ghule, S.B.; Salunkhe, V.P.; Chavan, V.; Sawant, S.D. Induction of systemic resistance in grapevines against powdery mildew by Trichoderma asperelloides strains. Australas. Plant Pathol. 2020, 49, 107–117. [Google Scholar] [CrossRef]
- Marques, A.P.G.C.; Pires, C.; Moreira, H.; Rangel, A.O.; Castro, P.M. Assessment of the plant growth promotion abilities of six bacterial isolates using Zea mays as indicator plant. Soil Biol. Biochem. 2010, 42, 1229–1235. [Google Scholar] [CrossRef]
- Marina, M.A.S.; Silva-Flores, M.A.; Uresti-Rivera, E.E.; Castro-Longoria, E.; Herrera-Estrella, A.; Casas-Flores, S. Colonization of Arabidopsis roots by Trichoderma atroviride promotes growth and enhances systemic disease resistance through jasmonic acid/ethylene and salicylic acid pathways. Eur. J. Plant Pathol. 2011, 131, 15–26. [Google Scholar] [CrossRef]
- Kotasthane, A.; Agrawal, T.; Kushwah, R.; Rahatkar, O.V. In-vitro antagonism of Trichoderma spp. against Sclerotium rolfsii and Rhizoctonia solani and their response towards growth of cucumber, bottle gourd and bitter gourd. Eur. J. Plant Pathol. 2015, 141, 523–543. [Google Scholar] [CrossRef]
- Ng, L.C.; Ngadin, A.; Azhari, M. Potential of Trichoderma spp. as Biological Control Agents Against Bakanae Pathogen (Fusarium fujikuroi) in Rice. Asian J. Plant Pathol. 2015, 9, 46–58. [Google Scholar] [CrossRef]
- Poonguzhali, S.; Madhaiyan, M.; Sa, T.M. Isolation and identification of phosphate solubilizing bacteria from Chinese cabbage and their effect on growth and phosphorus utilization of plants. J. Microbiol. Biotechnol. 2008, 18, 773–777. [Google Scholar]
- Majeed, A.; Abbasi, M.; Hameed, S. Isolation and characterization of plant growth-promoting rhizobacteria from wheat rhizosphere and their effect on plant growth promotion. Front. Microbiol. 2015, 6, 198. [Google Scholar] [CrossRef] [PubMed]
- Patten, C.; Glick, B.R. Bacterial biosynthesis of indole-3-acetic acid. Can. J. Microbiol. 1996, 42, 207–220. [Google Scholar] [CrossRef] [PubMed]
- Gilbert, S.; Xu, J.; Acosta, K.; Poulev, A.; Lebeis, S.; Lam, E. Bacterial Production of Indole Related Compounds Reveals Their Role in Association Between Duckweeds and Endophytes. Front. Chem. 2018, 6, 265. [Google Scholar] [CrossRef] [PubMed]
- Contreras-Cornejo, H.A.; Macias-Rodriguez, L.; Cortes-Penagos, C. Trichoderma virens, a plant beneficial fungus, enhances biomass production and promotes lateral root growth through an auxin-dependent mechanism in Arabidopsis. Plant Physiol. 2009, 149, 1579–1592. [Google Scholar] [CrossRef]
- Chowdappa, P.; Kumar, S.P.M.; Lakshmi, M.J.; Upreti, K.K. Growth stimulation and induction of systemic resistance in tomatoagainst early and late blight by Bacillus subtilis OTPB1 or Trichoderma harzianum OTPB. Biol. Control 2013, 65, 109–117. [Google Scholar] [CrossRef]
- Zhao, L.; Zhang, Y. Effects of phosphate solubilization and phytohormone production of Trichoderma asperellum Q1 on promoting cucumber growth under salt stress. J. Integr. Agric. 2015, 14, 1588–1597. [Google Scholar] [CrossRef]
- Perrig, D.; Boiero, M.L.; Masciarelli, O.A.; Penna, C.; Ruiz, O.A.; Cassán, F.D.; Luna, M.V. Plant-growth-promoting compounds produced by two agronomically important strains of Azospirillum brasilense, and implications for inoculant formulation. Appl. Microbiol. Biotechnol. 2007, 75, 1143–1150. [Google Scholar] [CrossRef] [PubMed]
- Chiwocha, S.D.S.; Abrams, S.R.; Ambrose, S.J.; Cutler, A.J.; Loewen, M.; Ross, A.R.S.; Kermode, A.R. A method for profiling classes of plant hormones and their metabolites using liquid chromatography-electrospray ionization tandem mass spectrometry: An analysis of hormone regulation of thermodormancy of lettuce (Lactuca sativa L.) seeds. Plant J. 2003, 35, 405–417. [Google Scholar] [CrossRef] [PubMed]
- Goswami, D.; Thakker, J.N.; Dhandhukia, P.C. Simultaneous detection and quantification of indole-3-acetic acid (IAA) and indole-3-butyric acid (IBA) produced by rhizobacteria from l-tryptophan (Trp) using HPTLC. J. Microbiol. Methods 2015, 110, 7–14. [Google Scholar] [CrossRef]
- Spaepen, S.; Vanderleyden, J. Auxin and plant-microbe interactions. Cold Spring Harb. Perspect. Biol. 2011, 3, a001438. [Google Scholar] [CrossRef] [PubMed]
- Yedidia, I.; Srivastva, A.K.; Kapulnik, Y. Effect of Trichoderma harzianum on microelement concentrations and increased growth of cucumber plants. Plant Soil 2001, 235, 235–242. [Google Scholar] [CrossRef]
- Fankem, H.; Nwaga, D.; Deubel, A.; Dieng, L.; Merbach, W.; Etoa, F.X. Occurrence and functioning of phosphate solubilizing microorganisms from oil palm tree (Elaeis guineensis) rhizosphere in Cameroon. Afr. J. Biotechnol. 2006, 5, 2450–2460. [Google Scholar]
- Ghosh, S.K.; Banerjee, S.; Pal, S. Encountering epidemic effects of leaf spot disease (Alternaria brassicae) on Aloe vera by fungal biocontrol agents in agri fields—An ecofriendly approach. PLoS ONE 2018, 13, e0193720. [Google Scholar] [CrossRef]
- El-Katatny, M.S. Inorganic phosphate solubilisation by free or immobilized Trichoderma harzianum cells in comparison with some other soil fungi. Egypt. J. Biotechnol. 2004, 17, 1338–1353. [Google Scholar]
- Lalngaihawmi, A.; Bhattacharyya, A. Study on the Different Modes of Action of Potential Trichoderma spp. from Banana Rhizosphere against Fusarium oxysporum f.sp. cubense. Int. J. Curr. Microbiol. Appl. Sci. 2019, 8, 1028–1040. [Google Scholar]
- Hassan, S.; Mathesius, U. The role of flavonoids in root–rhizosphere signalling: Opportunities and challenges for improving plant–microbe interactions. J. Exp. Bot. 2012, 63, 3429–3444. [Google Scholar] [CrossRef]
- Şesan, T.E.; Oancea, A.O.; Ştefan, L.M.; Mănoiu, V.S.; Ghiurea, M.; Răut, I.; Constantinescu-Aruxandei, D.; Toma, A.; Savin, S.; Bira, A.F.; et al. Effects of foliar treatment with a Trichoderma plant biostimulant consortium on Passiflora caerulea L. yield and quality. Microorganisms 2020, 8, 123. [Google Scholar] [CrossRef] [PubMed]
- Harman, G.E.; Petzoldt, R.; Comis, A.; Chen, J. Interactions Between Trichoderma harzianum Strain T22 and Maize Inbred Line Mo17 and Effects of These Interactions on Diseases Caused by Pythium ultimum and Colletotrichum graminicola. Phytopathology 2004, 94, 147–153. [Google Scholar] [CrossRef] [PubMed]
- Vinale, F.; Sivasithamparam, K.; Ghisalberti, E.L.; Marra, R.; Woo, S.L.; Lorito, M. Trichoderma–plant–pathogen interactions. Soil Biol. Biochem. 2008, 40, 1–10. [Google Scholar] [CrossRef]
- Garnica-Vergara, A.; Barrera-Ortiz, S.; Muñoz-Parra, E.; Raya-González, J.; Méndez-Bravo, A.; Macías-Rodríguez, L.; Ruiz-Herrera, L.F.; López-Bucio, J. The volatile 6-pentyl-2H-pyran-2-one from Trichoderma atroviride regulates Arabidopsis thaliana root morphogenesis via auxin signaling and ETHYLENE INSENSITIVE 2 functioning. N. Phytol. 2016, 209, 1496–1512. [Google Scholar] [CrossRef] [PubMed]
- Esparza-Reynoso, S.; Ruíz-Herrera, L.F.; Pelagio-Flores, R.; Macías-Rodríguez, L.I.; Martínez-Trujillo, M.; López-Coria, M.; Sánchez-Nieto, S.; Herrera-Estrella, A.; López-Bucio, J. Trichoderma atroviride-emitted volatiles improve growth of Arabidopsis seedlings through modulation of sucrose transport and metabolism. Plant Cell Environ. 2021, 44, 1961–1976. [Google Scholar] [CrossRef]
- Wonglom, P.; Ito, S.; Sunpapao, A. Volatile organic compounds emitted from endophytic fungus Trichoderma asperellum T1 mediate antifungal activity, defense response and promote plant growth in lettuce (Lactuca sativa). Fungal Ecol. 2020, 43, 100867. [Google Scholar] [CrossRef]
- Lemfack, M.C.; Gohlke, B.-O.; Toguem, S.M.T.; Preissner, S.; Piechulla, B.; Preissner, R. mVOC 2.0: A database of microbial volatiles. Nucleic Acids Res. 2018, 46, D1261–D1265. [Google Scholar] [CrossRef]
- Guo, Y.; Jud, W.; Ghirardo, A.; Antritter, F.; Benz, J.P.; Schnitzler, J.; Rosenkranz, M. Sniffing fungi—Phenotyping of volatile chemical diversity in Trichoderma species. N. Phytol. 2020, 227, 244–259. [Google Scholar] [CrossRef]
- Moya, P.; Girotti, J.R.; Toledo, A.V.; Sisterna, M.N. Antifungal activity of Trichoderma VOCs against Pyrenophora teres, the causal agent of barley net blotch. J. Plant Prot. Res. 2018, 58, 45–53. [Google Scholar]
- Malinich, E.A.; Wang, K.; Mukherjee, P.K.; Kolomiets, M.; Kenerley, C.M. Differential expression analysis of Trichoderma virens RNA reveals a dynamic transcriptome during colonization of Zea mays roots. BMC Genom. 2019, 20, 280. [Google Scholar] [CrossRef]
- Zhang, Y.; Xiao, J.; Yang, K.; Wang, Y.; Tian, Y.; Liang, Z. Transcriptomic and metabonomic insights into the biocontrol mechanism of Trichoderma asperellum M45a against watermelon Fusarium wilt. PLoS ONE 2022, 17, e0272702. [Google Scholar] [CrossRef] [PubMed]
- Zapparata, A.; Baroncelli, R.; Durling, M.B.; Kubicek, C.P.; Karlsson, M.; Vannacci, G.; Sarrocco, S. Fungal cross-talk: An integrated approach to study distance communication. Fungal Genet. Biol. 2021, 148, 103518. [Google Scholar] [CrossRef] [PubMed]
- Seidl, V.; Marchetti, M.; Schandl, R.; Allmaier, G.; Kubicek, C.P. Epl1, the major secreted protein of Hypocrea atroviridis on glucose, is a member of a strongly conserved protein family comprising plant defense response elicitors. FEBS J. 2006, 273, 4346–4359. [Google Scholar] [CrossRef] [PubMed]
- Djonović, S.; Vargas, W.A.; Kolomiets, M.V.; Horndeski, M.; Wiest, A.; Kenerley, C.M. A Proteinaceous Elicitor Sm1 from the Beneficial Fungus Trichoderma virens Is Required for Induced Systemic Resistance in Maize. Plant Physiol. 2007, 145, 875–889. [Google Scholar] [CrossRef] [PubMed]
- Palmieri, M.C.; Perazzolli, M.; Matafora, V.; Moretto, M.; Bachi, A.; Pertot, I. Proteomic analysis of grapevine resistance induced by Trichoderma harzianum T39 reveals specific defence pathways activated against downy mildew. J. Exp. Bot. 2012, 63, 6237–6251. [Google Scholar] [CrossRef]
- Gadaleta, A.; Colasuonno, P.; Giove, S.L.; Blanco, A.; Giancaspro, A. Map-based cloning of QFhb.mgb-2A identifies a WAK2 gene responsible for Fusarium Head Blight resistance in wheat. Sci. Rep. 2019, 9, 6929. [Google Scholar] [CrossRef]
- Chen, T.; Xiao, J.; Xu, J.; Wan, W.; Qin, B.; Cao, A.; Chen, W.; Xing, L.; Du, C.; Gao, X.; et al. Two members of TaRLK family confer powdery mildew resistance in common wheat. BMC Plant Biol. 2016, 16, 27. [Google Scholar] [CrossRef]
- Dmochowska-Boguta, M.; Kloc, Y.; Zielezinski, A.; Werecki, P.; Nadolska-Orczyk, A.; Karlowski, W.M.; Orczyk, W. TaWAK6 encoding wall-associated kinase is involved in wheat resistance to leaf rust similar to adult plant resistance. PLoS ONE 2020, 15, e0227713. [Google Scholar] [CrossRef]
- Guo, F.; Wu, T.; Shen, F.; Xu, G.; Qi, H.; Zhang, Z. The cysteine-rich receptor-like kinase TaCRK3 contributes to defense against Rhizoctonia cerealis in wheat. J. Exp. Bot. 2021, 72, 6904–6919. [Google Scholar] [CrossRef]
- Rubio, M.B.; de Alba, A.E.M.; Nicolás, C.; Monte, E.; Hermosa, R. Early Root Transcriptomic Changes in Wheat Seedlings Colonized by Trichoderma harzianum Under Different Inorganic Nitrogen Supplies. Front. Microbiol. 2019, 10, 2444. [Google Scholar] [CrossRef]
- Bienert, G.P.; Chaumont, F. Aquaporin-facilitated transmembrane diffusion of hydrogen peroxide. Biochim. Biophys. Acta (BBA) Gen. Subj. 2014, 1840, 1596–1604. [Google Scholar] [CrossRef] [PubMed]
- Li, G.; Chen, T.; Zhang, Z.; Li, B.; Tian, S. Roles of Aquaporins in Plant-Pathogen Interaction. Plants 2020, 9, 1134. [Google Scholar] [CrossRef] [PubMed]
- Safdarpour, F.; Khodakaramain, G. Endophytic bacteria suppress bacterial wilt of tomato. Caused by Ralstonia solanacearum and Activate defense–related metabolites. Biol. J. Microorg. 2018, 6, 39–52. [Google Scholar]
- Almagro, L.; Gómez Ros, L.V.; Belchi-Navarro, S.; Bru, R.; Ros Barceló, A.; Pedreño, M.A. Class III peroxidases in plant defence reactions. J. Exp. Bot. 2009, 60, 377–390. [Google Scholar] [CrossRef]
- Ali, S.; Ganai, B.A.; Kamili, A.N.; Bhat, A.A.; Mir, Z.A.; Bhat, J.A.; Tyagi, A.; Islam, S.T.; Mushtaq, M.; Yadav, P.; et al. Pathogenesis-related proteins and peptides as promising tools for engineering plants with multiple stress tolerance. Microbiol. Res. 2018, 212–213, 29–37. [Google Scholar] [CrossRef]
- Harman, G.E.; Howell, C.R.; Viterbo, A.; Chet, I.; Lorito, M. Trichoderma species—Opportunistic, avirulent plant symbionts. Nat. Rev. Genet. 2004, 2, 43–56. [Google Scholar] [CrossRef] [PubMed]
- Shoresh, M.; Harman, G.E.; Mastouri, F. Induced systemic resistance and plant responses to fungal biocontrol agents. Annu. Rev. Phytopathol. 2010, 48, 21–43. [Google Scholar] [CrossRef]
- Gomes, E.V.; Ulhoa, C.J.; Cardoza, R.E.; Silva, R.N.; Gutiérrez, S. Involvement of Trichoderma harzianum Epl-1 Protein in the Regulation of Botrytis Virulence- and Tomato Defense-Related Genes. Front. Plant Sci. 2017, 8, 880. [Google Scholar] [CrossRef]
- Pei, Y.; Li, X.; Zhu, Y.; Ge, X.; Sun, Y.; Liu, N.; Jia, Y.; Li, F.; Hou, Y. GhABP19, a Novel Germin-Like Protein From Gossypium hirsutum, Plays an Important Role in the Regulation of Resistance to Verticillium and Fusarium Wilt Pathogens. Front. Plant Sci. 2019, 10, 583. [Google Scholar] [CrossRef]
- Mathys, J.; De Cremer, K.; Timmermans, P.; Van Kerckhove, S.; Lievens, B.; Vanhaecke, M.; Cammue, B.P.A.; De Coninck, B. Genome-Wide Characterization of ISR Induced in Arabidopsis thaliana by Trichoderma hamatum T382 Against Botrytis cinerea Infection. Front. Plant Sci. 2012, 3, 108. [Google Scholar] [CrossRef]
- Rubio, M.B.; Quijada, N.M.; Pérez, E.; Domínguez, S.; Monte, E.; Hermosa, R. Identifying Beneficial Qualities of Trichoderma parareesei for Plants. Appl. Environ. Microbiol. 2014, 80, 1864–1873. [Google Scholar] [CrossRef]
- Martinez, C.; Blanc, F.; Le Claire, E.; Besnard, O.; Nicole, M.; Baccou, J.-C. Salicylic Acid and Ethylene Pathways Are Differentially Activated in Melon Cotyledons by Active or Heat-Denatured Cellulase from Trichoderma longibrachiatum. Plant Physiol. 2001, 127, 334–344. [Google Scholar] [CrossRef] [PubMed]
- Korolev, N.; David, D.R.; Elad, Y. The role of phytohormones in basal resistance and Trichoderma-induced systemic resistance to Botrytis cinerea in Arabidopsis thaliana. BioControl 2008, 53, 667–683. [Google Scholar] [CrossRef]
- Medina, M.H.J.; Gagnon, H.; Piché, Y.; Ocampo, J.A.; Garcıa, G.J.M.; Vierheilig, H. Root colonization by arbuscular mycorrhizal fungi is affected by the salicylic acid content of the plant. Plant Sci. 2003, 164, 993–998. [Google Scholar] [CrossRef]
- Alonso-Ramírez, A.; Poveda, J.; Martín, I.; Hermosa, R.; Monte, E.; Nicolás, C. Salicylic acid prevents Trichoderma harzianum from entering the vascular system of roots. Mol. Plant Pathol. 2014, 15, 823–831. [Google Scholar] [CrossRef] [PubMed]
- Peleg-Grossman, S.; Golani, Y.; Kaye, Y.; Melamed-Book, N.; Levine, A. NPR1 Protein Regulates Pathogenic and Symbiotic Interactions between Rhizobium and Legumes and Non-Legumes. PLoS ONE 2009, 4, e8399. [Google Scholar] [CrossRef] [PubMed]
- Lopez-Raez, J.A.; Verhage, A.; Fernandez, I.; García, J.M.; Azcon-Aguilar, C.; Flors, V.; Pozo, M.J. Hormonal and transcriptional profiles highlight common and differential host responses to arbuscular mycorrhizal fungi and the regulation of the oxylipin pathway. J. Exp. Bot. 2010, 61, 2589–2601. [Google Scholar] [CrossRef]
- Viterbo, A.; Landau, U.; Kim, S.; Chernin, L.; Chet, I. Characterization of ACC deaminase from the biocontrol and plant growth-promoting agent Trichoderma asperellum T203. FEMS Microbiol. Lett. 2010, 305, 42–48. [Google Scholar] [CrossRef]
- Jaroszuk-Ściseł, J.; Tyśkiewicz, R.; Nowak, A. Phytohormones (auxin, gibberellin) and ACC deaminase in vitro synthesized by the mycoparasitic Trichoderma DEMTkZ3A0 strain and changes in the level of auxin and plant resistance markers in wheat seedlings inoculated with this strain conidia. Int. J. Mol. Sci. 2019, 20, 4923. [Google Scholar] [CrossRef]
- Król, P.; Igielski, R.; Pollmann, S.; Kępczyńska, E. Priming of seeds with methyl jasmonate induced resistance to hemibiotroph Fusarium oxysporum f. sp. lycopersici in tomato via 12-oxo-phytodienoic acid, salicylic acid, and flavonol accumulation. J. Plant Physiol. 2015, 179, 122–132. [Google Scholar] [CrossRef]
- Sahu, R.; Sharaff, M.; Pradhan, M.; Sethi, A.; Bandyopadhyay, T.; Mishra, V.K.; Chand, R.; Chowdhury, A.K.; Joshi, A.K.; Pandey, S.P. Elucidation of defense-related signaling responses to spot blotch infection in bread wheat (Triticum aestivum L.). Plant J. 2016, 86, 35–49. [Google Scholar] [CrossRef]
- Singh, U.B.; Malviya, D.; Singh, S.; Kumar, M.; Sahu, P.K.; Singh, H.V.; Kumar, S.; Roy, M.; Imran, M.; Rai, J.P.; et al. Trichoderma harzianum- and Methyl Jasmonate-Induced Resistance to Bipolaris sorokiniana Through Enhanced Phenylpropanoid Activities in Bread Wheat (Triticum aestivum L.). Front. Microbiol. 2019, 10, 1697. [Google Scholar] [CrossRef]
- Kepczynska, E.; Kepczynski, J. Inhibitory effect of metyl jasmonates on developmentof phythopathogen Alternaria alternata (Fr.) Keissl. and its reversal by ethephon and ACC. Acta Physiol. Plant 2005, 27, 491–496. [Google Scholar]
- Kepczynska, E.; Król, P. The phytohormone methyl jasmonate as an activator of induced resistance against the necrotroph Alternaria porri f.sp. solani in tomato plants. J. Plant Interact. 2012, 7, 307–315. [Google Scholar] [CrossRef]
- Švecová, E.; Proietti, S.; Caruso, C.; Colla, G.; Crinò, P. Antifungal activity of Vitex agnus-castus extract against Pythium ultimum in tomato. Crop. Prot. 2013, 43, 223–230. [Google Scholar] [CrossRef]
- Samolski, I.; Rincón, A.M.; Pinzón, L.M.; Viterbo, A.; Monte, E. The qid74 gene from Trichoderma harzianum has a role in root architecture and plant biofertilization. Microbiology 2012, 158, 129–138. [Google Scholar] [CrossRef] [PubMed]
- Ruano-Rosa, D.; Prieto, P.; Rincón, A.M.; Gómez-Rodríguez, M.V.; Valderrama, R.; Barroso, J.B.; Mercado-Blanco, J. Fate of Trichoderma harzianum in the olive rhizosphere: Time course of the root colonization process and interaction with the fungal pathogen Verticillium dahliae. Biocontrol 2016, 61, 269–282. [Google Scholar] [CrossRef]
- Basińska-Barczak, A.; Błaszczyk, L.; Szentner, K. Plant Cell Wall Changes in Common Wheat Roots as a Result of Their Interaction with Beneficial Fungi of Trichoderma. Cells 2020, 9, 2319. [Google Scholar] [CrossRef] [PubMed]
- Ganuza, M.; Pastor, N.; Boccolini, M.; Erazo, J.; Palacios, S.; Oddino, C.; Reynoso, M.; Rovera, M.; Torres, A. Evaluating the impact of the biocontrol agent Trichoderma harzianum ITEM 3636 on indigenous microbial communities from field soils. J. Appl. Microbiol. 2019, 126, 608–623. [Google Scholar] [CrossRef]
- Illescas, M.; Rubio, M.B.; Hernández-Ruiz, V.; Morán-Diez, M.E.; de Alba, A.E.M.; Nicolás, C.; Monte, E.; Hermosa, R. Effect of Inorganic N Top Dressing and Trichoderma harzianum Seed-Inoculation on Crop Yield and the Shaping of Root Microbial Communities of Wheat Plants Cultivated Under High Basal N Fertilization. Front. Plant Sci. 2020, 11, 575861. [Google Scholar] [CrossRef]
- Friedl, M.A.; Druzhinina, I.S. Taxon-specific metagenomics of Trichoderma reveals a narrow community of opportunistic species that regulate each other’s development. Microbiology 2012, 158, 69–83. [Google Scholar] [CrossRef] [PubMed]
- Singh, A.; Lasek-Nesselquist, E.; Chaturvedi, V.; Chaturvedi, S. Trichoderma polysporum selectively inhibits white nose syndrome fungal pathogen Pseudogymmnoascus destructans amidst soil microbes. Microbiome 2018, 6, 319. [Google Scholar] [CrossRef] [PubMed]
- Martínez-Medina, A.; Fernández, I.; Sánchez-Guzmán, M.J.; Jung, S.C.; Pascual, J.A.; Pozo, M.J. Deciphering the hormonal signalling network behind the systemic resistance induced by Trichoderma harzianum in tomato. Front. Plant Sci. 2013, 4, 206. [Google Scholar] [CrossRef]
- Leonetti, P.; Zonno, M.C.; Molinari, S.; Altomare, C. Induction of SA-signaling pathway and ethylene biosynthesis in Trichoderma harzianum-treated tomato plants after infection of the root-knot nematode Meloidogyne incognita. Plant Cell Rep. 2017, 36, 621–631. [Google Scholar] [CrossRef]
- Van Wees, S.C.; De Swart, E.A.; Van Pelt, J.A.; Van Loon, L.C.; Pieterse, C.M. Enhancement of induced disease resistance by simultaneous activation of salicylate- and jasmonate-dependent defense pathways in Arabidopsis thaliana. Proc. Natl. Acad. Sci. USA 2000, 97, 8711–8716. [Google Scholar] [CrossRef] [PubMed]
- Mur, L.A.; Kenton, P.; Atzorn, R.; Miersch, O.; Wasternack, C. The Outcomes of Concentration-Specific Interactions between Salicylate and Jasmonate Signaling Include Synergy, Antagonism, and Oxidative Stress Leading to Cell Death. Plant Physiol. 2006, 140, 249–262. [Google Scholar] [CrossRef]
- Illescas, M.; Pedrero-Méndez, A.; Pitorini-Bovolini, M.; Hermosa, R.; Monte, E. Phytohormone Production Profiles in Trichoderma Species and Their Relationship to Wheat Plant Responses to Water Stress. Pathogens 2021, 10, 991. [Google Scholar] [CrossRef]
- Alfano, G.; Ivey, M.L.L.; Cakir, C.; Bos, J.I.B.; Miller, S.A.; Ma, S.; Kamoun, S.; Hoitink, H.A.J.; Alfano, M.L.L.I.G.; Uddin, M.N.; et al. Systemic Modulation of Gene Expression in Tomato by Trichoderma hamatum 382. Phytopathology 2007, 97, 429–437. [Google Scholar] [CrossRef]
- Segarra, G.; Jáuregui, O.; Casanova, E.; Trillas, I. Simultaneous quantitative LC–ESI-MS/MS analyses of salicylic acid and jasmonic acid in crude extracts of Cucumis sativus under biotic stress. Phytochemistry 2006, 67, 395–401. [Google Scholar] [CrossRef]
- Attaran, E.; Major, I.T.; Cruz, J.A.; Rosa, B.A.; Koo, A.; Chen, J.; Kramer, D.; He, S.Y.; Howe, G.A. Temporal Dynamics of Growth and Photosynthesis Suppression in Response to Jasmonate Signaling. Plant Physiol. 2014, 165, 1302–1314. [Google Scholar] [CrossRef]
- Huot, B.; Yao, J.; Montgomery, B.L.; He, S.Y. Growth–Defense Tradeoffs in Plants: A Balancing Act to Optimize Fitness. Mol. Plant 2014, 7, 1267–1287. [Google Scholar] [CrossRef] [PubMed]

| Species | Strain/Isolate | ITS | tef1 | rpb2 |
|---|---|---|---|---|
| T. afroharzianum | Tahz01 a | OP970986 | OR039793 | OR039787 |
| T. afroharzianum | Tahz02 a | OP970987 | OR039794 | OR039788 |
| T. afroharzianum | Tahz01 a | OP970990 | OR039795 | OR039789 |
| T. atrobrunneum | Tatr03 a | OP970988 | OR039796 | OR039790 |
| T. lentinulae | Tlen01 a | OP970991 | OR039797 | OR039791 |
| T. lixii | Tlix01 a | OP970989 | OR039798 | OR039792 |
| T. afroharzianum | Tafum1 | MT102401.1 | MT081431.1 | MT118246.1 |
| T. afroharzianum | Tri-1 | MT793748.1 | OP102131.1 | OP102132.1 |
| T. atrobrunneum | T39 | MG952890.1 | KX632628.1 | KX632571.1 |
| T. lentinulae | CGMCC 3.19699 | MN594478.1 | MN605887.1 | MN605876.1 |
| T. lentinulae | CGMCC 3.19847 | MN594469.1 | MN605878.1 | MN605867.1 |
| T. lixii | C.P.K. 1934 | EF392746.2 | FJ179573.1 | MT587315.1 |
| T. lixii | TLiC8 | MT434003.1 | MT587276.1.1 | MT587315.1 |
| T. reesei | CBS999.97 | CP020878.1 | CP020876.1 | CP017984.1 |
| T. atroviride | TRS18 | KJ786757.1 | KJ786839.1 | KP009061.1 |
| T. longibrachiatum | Tloum3 | MT102396.1 | MT081437.1 | MT118251.1 |
| Strains | Phosphate Solubilization | Indole-like Compounds Production (μg·mL−1) | Ammonia Production (μg·mL−1) | HCN Production |
|---|---|---|---|---|
| Tahz01 | - | 4.16 ± 1.76 b | 16.7 ± 1.2 a | - |
| Tahz02 | - | 12.43 ± 6.56 a | 15.9 ± 0.3 a | - |
| Tahz03 | - | 0.93 ± 1.35 d | 14.4 ± 1.4 a | - |
| Tatr01 | - | 1.7 ± 0.2 c | 14.1 ± 1.5 a | - |
| Tlen01 | - | 1.1 ± 1.81 ed | 14.8 ± 1.1 a | - |
| Tlix01 | - | - | 14.4 ± 2.4 a | - |
Disclaimer/Publisher’s Note: The statements, opinions and data contained in all publications are solely those of the individual author(s) and contributor(s) and not of MDPI and/or the editor(s). MDPI and/or the editor(s) disclaim responsibility for any injury to people or property resulting from any ideas, methods, instructions or products referred to in the content. |
© 2023 by the authors. Licensee MDPI, Basel, Switzerland. This article is an open access article distributed under the terms and conditions of the Creative Commons Attribution (CC BY) license (https://creativecommons.org/licenses/by/4.0/).
Share and Cite
Saadaoui, M.; Faize, M.; Bonhomme, L.; Benyoussef, N.O.; Kharrat, M.; Chaar, H.; Label, P.; Venisse, J.-S. Assessment of Tunisian Trichoderma Isolates on Wheat Seed Germination, Seedling Growth and Fusarium Seedling Blight Suppression. Microorganisms 2023, 11, 1512. https://doi.org/10.3390/microorganisms11061512
Saadaoui M, Faize M, Bonhomme L, Benyoussef NO, Kharrat M, Chaar H, Label P, Venisse J-S. Assessment of Tunisian Trichoderma Isolates on Wheat Seed Germination, Seedling Growth and Fusarium Seedling Blight Suppression. Microorganisms. 2023; 11(6):1512. https://doi.org/10.3390/microorganisms11061512
Chicago/Turabian StyleSaadaoui, Mouadh, Mohamed Faize, Ludovic Bonhomme, Noura Omri Benyoussef, Mohamed Kharrat, Hatem Chaar, Philippe Label, and Jean-Stéphane Venisse. 2023. "Assessment of Tunisian Trichoderma Isolates on Wheat Seed Germination, Seedling Growth and Fusarium Seedling Blight Suppression" Microorganisms 11, no. 6: 1512. https://doi.org/10.3390/microorganisms11061512
APA StyleSaadaoui, M., Faize, M., Bonhomme, L., Benyoussef, N. O., Kharrat, M., Chaar, H., Label, P., & Venisse, J.-S. (2023). Assessment of Tunisian Trichoderma Isolates on Wheat Seed Germination, Seedling Growth and Fusarium Seedling Blight Suppression. Microorganisms, 11(6), 1512. https://doi.org/10.3390/microorganisms11061512

